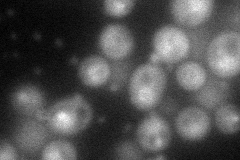
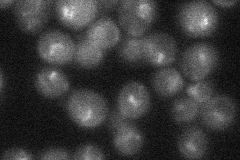
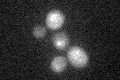

View description
Protein involved in promoting high level transcription of rDNA, subunit of UAF (upstream activation factor) for RNA polymerase I
Localization:
Intensity:
Fold change:
Significance:
-
C’ GFP library in SD

below threshold14.96 -
N' NOP1pr-GFP in SD
below threshold60.3416 -
N' TEF2pr-mCherry in SD

punctate10.0899 -
N' NATIVEpr-GFP in SD
punctate,nucleus28.2091 -
N' TEF2pr-VC and Cyto-VN in SD

below threshold23.4708 -
C’ GFP library in SD+DTT
cytosol15.991.06No -
C’ GFP library in SD+H2O2

cytosol16.941.13No -
C’ GFP library in Starvation Media

cytosol27.271.82No -
C’ GFP library on the background of Pup2-DaMP

below threshold -
C’ GFP library on the background of CCT mutant

below threshold15.28731.02149No
